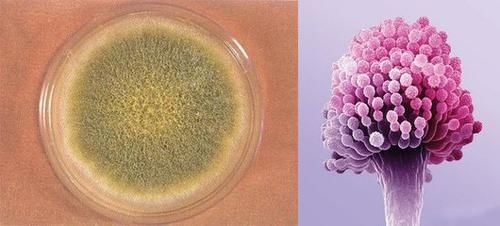
毒素|大家多注意!毒性是砒霜的68倍,可致癌,生活中我们经常看到

哈喽,终于等到您,还好我没放弃!您终于来了!这里有您最想知道的!这里有您最想不到的!这里有您在别的地方看不到的!总之,您来对地方了~那么下面就让我带您一起看看下面的文章!
黄曲霉毒素,是一种毒性极强的剧毒物质,其毒性是砒霜的68倍,是氰化钾的10倍,对肝脏组织的破坏性极强。1993年它就被世界卫生组织的癌症研究机构划定为1类致癌物。 最让人无奈的是,这种剧毒致癌物就存在于我们的日常生活中。

文章插图
世界范围内黄曲霉毒素的污染相当广泛,包括谷物、坚果和籽类以及牛乳等,尤以玉米、花生被污染的程度最严重。其主要原因是食物在田间未收获前被黄曲霉等产毒菌浸染,在适宜的气温和湿度等条件下繁殖并产毒,或未经充分干燥,在储藏期间产生大量毒素,以下几种食物里面最容易出现黄曲霉毒素,大家多注意!
文章插图
1:发霉的花生玉米:黄曲霉素藏在发霉的食物里,特别是淀粉含量高的食物里,比如花生、玉米等。如果您发现有一颗花生坏了,那一碗花生米,或者是存放的一袋子的花生米都得扔掉。
2:变质的米饭:别以为做熟了就能放松警惕,变质的米饭是最容易产生黄曲霉毒素的!
3:发苦的坚果:如果吃到变苦的瓜子,一定要及时吐掉并且漱口,因为瓜子等坚果的苦味正是来自霉变过程中产生的黄曲霉毒素,经常摄入会增加肝癌风险。
【 毒素|大家多注意!毒性是砒霜的68倍,可致癌,生活中我们经常看到】

文章插图
4:没洗干净的筷子:很多家庭也都有这个习惯,筷子用到细缝发黑都不舍得扔掉,筷子缝里最容易藏淀粉,一来二去霉变了,黄曲霉素就藏在里面了。
5:劣质芝麻酱:有些商家为了降低成本,用糠芝麻、瘪花生甚至变质的芝麻、花生做原料,其中变质的花生中含有黄曲霉毒素。
7:久泡的木耳:木耳在泡发过程产生何种细菌或毒素,需要进行进一步的检测和判断。可能有哪些微生物毒素呢?譬如黄曲霉毒素、青霉毒素等。

文章插图
黄曲霉素中毒分急性和慢性两种。一次性大量服用黄曲霉素会引起肝损伤以及神经中毒(意识混乱,昏迷等)。慢性中毒则是长期小剂量地服用黄曲霉,长期黄曲霉的影响下,会造成DNA碱基变异,可能引起癌症。 所以生活中多注意饮食卫生,确保饮食安全,特别是照顾小孩的时候。
小编有话说:很多人将生活不愉快,生活不顺利都会归咎到自己命不好上面,这是不对的。不管是有十个斗,还是十个簸箕,当你握住手掌的时候,这些东西都被你握在了自己的手里,所以命运掌握在自己手里,人的命运还是要靠自己改变的,不是由上天决定的,哪吒还说过“我命有无不由天”呢。你想要以后的生活富足,那么你现在就要开始奋斗,为自己积攒财富和资源。你要是想着不劳而获,是不可能的。你的路要靠自己走,想过什么样的人生也是自己的选择,只要选择好自己要走的路,踏踏实实的,一步一个脚印,哪怕手上一个斗都没有,也不一定将来会比别人差。小编的十个手指的指纹就都是“簸箕”,但是小编就从来不觉得自己是一个命苦的人,也从来不觉得我的命运会被指纹所掌控。
- 延缓衰老|女性衰老“减速带”公布,多喝水排第4,第1名很多姐妹难以坚持
 - 葡萄柚|对女人最好的水果,每天吃一种,排毒养颜,淡化黑眼圈,好处多多
 - 慢性疾病|301医院营养科教授:人到老年3种肉要忌口,但有些肉要多吃些
 - 电磁炉|有些老人70多岁就去世了,有些老人80多岁身体还很好,是什么原因
 - 银耳|入秋记得多吃银耳,教你简单煮法,银耳出胶浓稠,一人一碗,好喝
 - 发生率|预防肠癌,要牢记“2少3多4不做”,或许可以让肠道保持健康
 - 提高免疫力|孩子身体湿气重整天都怕冷,多吃暖身菜,祛湿暖身身体健康
 - 血液循环|女性多吃此菜,再贵也别省,润肠通便,促进血液循环,了解下
 - 黄金时间|多走路就能长寿?专家提醒:过了45岁,这几件事比走路更重要
 - 羊肉|孩子写了一天的作业眼睛都学累了,多吃护眼菜,缓解眼睛疲劳
 
